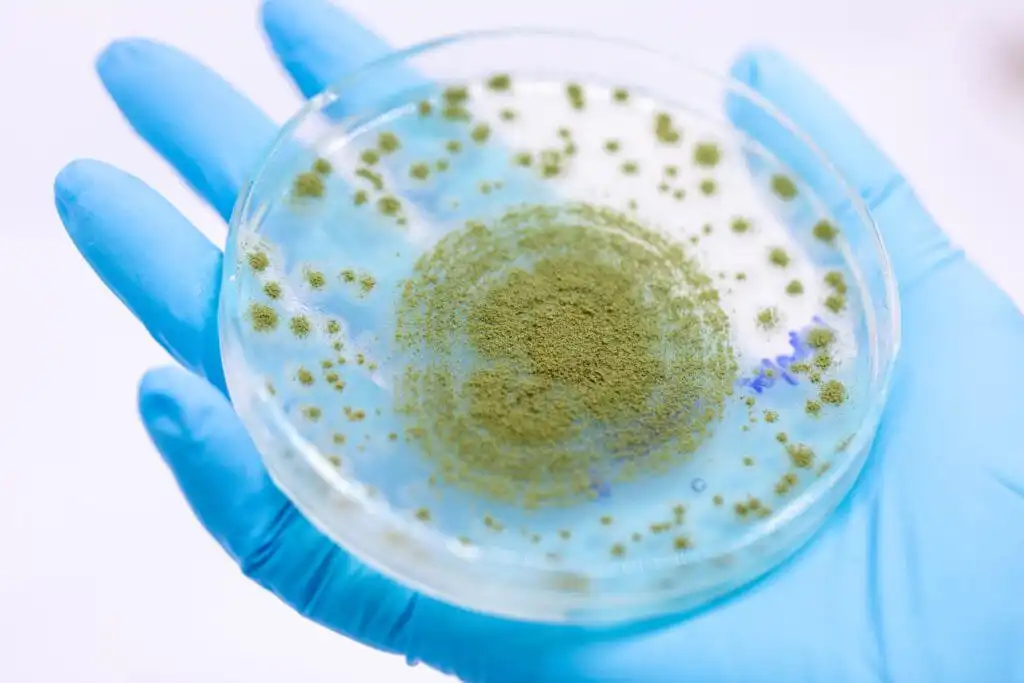

Aspergillosis in Ducks: Causes, Symptoms, Prevention, and Treatment
Last updated: February 17th, 2026
To keep our research-backed guides free, this site uses ads and affiliate links (earning a small commission at no cost to you). Everything here is created by a duck mom and PhD scientist, combining academic rigor with hands-on experience to provide practical, trustworthy advice for duck keepers everywhere. 🦆 Learn more
Aspergillosis is one of the most serious fungal infections affecting ducks, particularly ducklings and immunocompromised birds. Caused primarily by Aspergillus fumigatus, a ubiquitous environmental mold, this disease develops when spores are inhaled and establish infection in the respiratory tract.
Unlike many bacterial or viral diseases, aspergillosis is not contagious between ducks. Instead, it is an environmental disease. Mold spores thrive in damp bedding, poorly stored feed, wet straw, and poorly ventilated housing. Once inhaled, they can colonize the lungs and air sacs, leading to progressive respiratory distress.
Ducklings are especially vulnerable because their immune systems are still developing. However, adult ducks exposed to high spore loads or chronic moisture can also become affected.
Respiratory fungal infections can progress quietly before becoming obvious. Early detection and environmental management are critical.
Prevention begins with dry, clean, well ventilated housing and proper feed storage.
Ducks of Providence is free, thanks to reader support! Ads and affiliate links help us cover costs—if you shop through our links, we may earn a small commission at no extra cost to you. Thanks for helping keep our content free and our ducks happy! 🦆 Learn more
This article is part of our Duck Health Conditions Series and part of the Duck Health & Anatomy Hub, Evidence-based medical resources and anatomical research.
What is Aspergillosis?
Aspergillosis is an infection caused by fungi from the genus Aspergillus, a group of molds found in the environment. These fungi are opportunistic pathogens, meaning they typically infect animals with weakened immune systems or those exposed to high concentrations of fungal spores. In ducks, aspergillosis primarily affects the respiratory system but can spread to other organs in severe cases.
About Aspergillus: The Fungus Behind the Disease
Characteristics of Aspergillus
- Wide distribution: Aspergillus species are ubiquitous, commonly found in soil, decaying vegetation, compost, and moldy feed or bedding.
- Hardy spores: The fungus reproduces via microscopic spores called conidia, which are lightweight and can easily become airborne.
- Versatility: These fungi thrive in warm, moist environments but can survive in a range of conditions, making them highly resilient.

The Lifecycle of Aspergillus
Understanding its lifecycle sheds light on why it poses a significant risk to ducks in certain environments.
- Spore Formation:
Aspergillus reproduces asexually through the production of conidia, which are formed at the tips of specialized hyphae called conidiophores. These spores are released into the air. - Spore Dispersal:
The lightweight conidia are carried by air currents and can remain suspended for long periods. Ducks inhale these spores while foraging, drinking, or simply breathing in contaminated environments. - Germination:
If the spores land on a suitable substrate (e.g., damp bedding or organic material), they germinate, forming hyphae, the thread-like structures that make up the fungal body. - Hyphal Growth and Colonization:
The hyphae grow rapidly, penetrating organic material and breaking it down for nutrients. In the host (such as a duck), these hyphae invade tissues, causing inflammation and damage. - Reproduction:
Once the fungus has established itself, it produces more conidiophores, releasing additional spores into the environment and perpetuating the cycle.
Why Aspergillus is Harmful to Ducks
- Inhalation Hazard: Ducks are especially vulnerable due to their constant interaction with moist environments where spores proliferate.
- Immune System Impact: Healthy ducks can typically resist low levels of spores, but stress, illness, or high spore concentrations overwhelm their defenses.
- Respiratory Invasion: Inhaled spores germinate in the air sacs and lungs, causing severe inflammation and tissue damage.
Key Species of Aspergillus in Aspergillosis
While several species of Aspergillus can cause disease, the most common culprits are:
- Aspergillus fumigatus: The leading cause of aspergillosis in animals and humans, known for its ability to grow at body temperature.
- Aspergillus flavus: Often found in moldy feed and grains, producing toxins like aflatoxins in addition to causing infections.
- Aspergillus niger: Occasionally implicated in respiratory disease.
Environmental Conditions Favoring Aspergillus Growth
- Warm temperatures: Optimal growth occurs between 77°F and 104°F (25°C and 40°C).
- High humidity: Damp conditions, such as in poorly maintained bedding or feed storage areas.
- Organic matter: Decomposing vegetation, straw, or grain provides nutrients for fungal growth.
By disrupting the lifecycle, keeping duck environments dry, clean, and well-ventilated, we can minimize the risk of exposure and keep our feathered friends safe from this persistent fungal foe.

Causes and Risk Factors in Ducks
Aspergillosis is a serious fungal infection caused by inhaling airborne spores from the fungus Aspergillus, which thrives in warm, humid environments, particularly at temperatures of 77°F (25°C) or above. Ducks are especially vulnerable, being 200 times more susceptible than chickens, making proper management essential to prevent the disease. A variety of environmental and health factors can exacerbate the risk of infection, including:
Environmental Factors
- Poor Ventilation
Ducks need well-ventilated housing to prevent the buildup of heat and moisture, which creates the perfect conditions for fungal growth. Overcrowding in poorly ventilated spaces further traps airborne spores, increasing exposure. - Inadequate Sanitation
Mold and fungal spores flourish in damp bedding, dirty enclosures, or wet feed. Bedding materials like straw or wood shavings, when left unchanged for too long, can act as reservoirs for Aspergillus spores. - Low-Quality Feed
Feeding ducks mold-contaminated or spoiled grains introduces Aspergillus spores directly into their environment. Moldy feed is one of the leading sources of infection in flocks. - Improper Feed Storage
Even high-quality feed can become a risk if stored improperly. Damp conditions in feed storage areas promote fungal growth, turning nutritious feed into a potential health hazard. Storing feed in a cool, dry location and inspecting it regularly can prevent this.

Health and Dietary Factors
- Vitamin Deficiencies
Ducks lacking adequate levels of essential vitamins, particularly vitamin A, have weakened immune systems, making them less capable of fighting off fungal infections. Vitamin A plays a critical role in maintaining healthy mucous membranes, which are a primary defense against fungal invasion. - Prolonged Use of Antibiotics or Steroids
Long-term treatments with antibiotics or steroids can suppress a duck’s immune system, leaving it more susceptible to opportunistic infections like aspergillosis. While such medications may be necessary at times, their use should be carefully monitored by a veterinarian.
Why Ducks Are at Higher Risk
Ducks’ unique behaviors and respiratory anatomy contribute to their heightened susceptibility. Foraging in wet environments and dabbling in water frequently expose them to damp, mold-prone conditions. Additionally, their respiratory system, which includes a series of air sacs, provides an ideal site for Aspergillus spores to settle and grow.

Can Aspergillosis Spread to Other Ducks?
Aspergillosis is not contagious between ducks but stems from environmental exposure. However, if one duck shows symptoms, it’s essential to inspect their environment to prevent others from being exposed.
By addressing these risk factors through proper sanitation, ventilation, feed management, and nutritional support, duck keepers can greatly reduce the chances of aspergillosis in their flocks and ensure the well-being of their feathered companions.
Symptoms of Aspergillosis in Ducks
The symptoms of aspergillosis in ducks can vary depending on the severity and progression of the infection. While the disease primarily affects the respiratory system, chronic cases can impact other organs and lead to systemic illness. Recognizing the signs early can make a significant difference in treatment outcomes. Ducks infected with aspergillosis may exhibit:
Respiratory Symptoms
- Difficulty Breathing: Ducks may show open-mouth breathing, gasping, or wheezing. Severe respiratory distress (dyspnea) can lead to visible tail bobbing, a telltale sign of a struggling respiratory system.
- Discharge: Look for unusual discharge from the nose or eyes, which can indicate an upper respiratory tract infection caused by the fungus.
- Cyanosis: A bluish discoloration of the skin or mucous membranes (often noticeable on the bill or feet) caused by a lack of oxygen in the blood due to impaired lung function.

General Symptoms
- Lethargy: Infected ducks may appear listless, with reduced activity levels or reluctance to move.
- Ruffled Feathers: Feathers may appear unkempt or fluffed up as the duck’s body reacts to illness.
- Loss of Appetite: Ducks may stop eating entirely or show a decreased interest in food, sometimes compensating by drinking excessively.
- Weight Loss: Particularly noticeable in chronic cases, as the duck’s body struggles to fight the infection.
Severe and Chronic Symptoms
- Sudden Death: In severe, acute cases, ducks may succumb to the infection without showing noticeable symptoms beforehand.
- Systemic Impact: Chronic cases can affect other organs, leading to further complications like weakness, poor egg production, or generalized illness.
Upper vs. Lower Respiratory Involvement
Aspergillosis can affect both the upper respiratory tract (nose, sinuses, and throat) and the lower respiratory tract (lungs and air sacs). Upper respiratory infections may present with nasal discharge and sneezing, while lower respiratory infections are more likely to cause gasping, wheezing, and cyanosis.
Pro Tip: Tail bobbing, combined with open-mouth breathing, is a key indicator of respiratory distress in ducks and warrants immediate veterinary attention.
Understanding these symptoms and acting quickly when they appear can improve the chances of successful treatment and recovery for your ducks.

Diagnosis of Aspergillosis in Ducks
Diagnosing aspergillosis in ducks requires a combination of clinical evaluation, laboratory tests, and in some cases, postmortem examination. Because the symptoms can resemble other respiratory illnesses, a veterinarian’s expertise is essential to confirm the presence of the Aspergillus fungus.
Methods of Diagnosis
- Physical Examination
- A thorough physical examination may reveal signs such as difficulty breathing, wheezing, or open-mouth breathing.
- A veterinarian may use a stethoscope to listen for abnormal lung sounds, such as crackles or reduced airflow, which are indicative of respiratory distress.
- X-rays (Radiography)
- X-rays can help identify fungal growths or granulomas in the lungs, air sacs, or other internal organs.
- Radiographs are particularly useful for visualizing dense areas of infection that might not be evident through external examination.
- Blood Tests
- Bloodwork can detect signs of infection or inflammation, such as elevated white blood cell counts.
- Changes in certain blood parameters may indicate a systemic response to fungal infection.
- Fungal Cultures
- Samples from respiratory discharge, tissue, or lesions can be cultured in a laboratory to confirm the presence of the Aspergillus fungus.
- Fungal cultures provide a definitive diagnosis but may take time to yield results.
- Postmortem Examination (if necessary)
- In severe cases where the duck has succumbed to the disease, a necropsy can provide critical diagnostic insights.
- The presence of whitish to creamy caseous nodules in the lungs, air sacs, and sometimes other organs is a hallmark sign of aspergillosis.
- Granulomatous lesions in tissues such as the lungs and liver are commonly observed, confirming fungal invasion and the body’s immune response.

Why Accurate Diagnosis is Crucial
Aspergillosis symptoms overlap with other respiratory and systemic diseases, such as bacterial infections or parasitic infestations, making it vital to confirm the diagnosis before starting treatment. Prompt and accurate identification of aspergillosis allows for targeted interventions, increasing the likelihood of recovery and preventing further spread within the flock.
If you suspect aspergillosis in your ducks, consult a veterinarian as soon as possible to ensure a proper diagnosis and appropriate care.
Treatment of Aspergillosis in Ducks
Treating aspergillosis in ducks can be challenging, as the fungal spores are resilient and often difficult to eradicate completely. Success largely depends on early detection, prompt intervention, and supportive care to strengthen the duck’s immune system. While antifungal medications are the cornerstone of treatment, addressing environmental factors and providing supportive therapies are equally important.
Immediate Care and Isolation
- Isolate the affected duck from the flock to prevent stress and secondary complications.
- Place the duck in a safe, comfortable, and warm location, essentially a duck “intensive care unit.”
- Ensure easy access to fresh water and nutritious food to support recovery.
- Limit stress by maintaining a quiet, calm environment.
- Contact a veterinarian for diagnosis and guidance on appropriate treatment.

Key Treatment Strategies
- Antifungal Medications
- Fungicides: Medications such as copper sulfate can be used to combat the fungal infection. These are often administered under veterinary supervision to ensure proper dosing and minimize side effects.
- Itraconazole or Amphotericin B: Prescription antifungal drugs are commonly used for severe cases. These medications are highly effective but may require prolonged treatment periods.
- Antibiotics for Secondary Infections
- Ducks with aspergillosis are at an increased risk of secondary bacterial infections due to their weakened immune systems. Broad-spectrum antibiotics may be prescribed to prevent or treat these complications.
- Nutritional Support
- Multivitamins: Supplementation with vitamins, especially A, C, and E, can help bolster the duck’s immune system and aid recovery.
- Adequate nutrition plays a critical role in supporting the duck’s body during the treatment process.
- Respiratory Support
- Ducks with severe respiratory distress may benefit from nebulization therapy. This involves inhaling antifungal or supportive medications through a nebulizer to deliver treatment directly to the lungs and air sacs.
- Environmental Management
- The duck’s living environment must be cleaned and disinfected thoroughly to reduce exposure to Aspergillus spores.
- Improving ventilation and ensuring dry, clean bedding can help minimize fungal growth and prevent reinfection.

Challenges in Treatment
- The resilience of fungal spores makes complete eradication difficult, especially if the duck continues to be exposed to contaminated environments.
- Advanced cases, particularly those with systemic infections, may require long-term treatment and intensive care.
Holistic Management Approach
While medication is crucial, comprehensive management includes addressing the underlying causes that led to the outbreak:
- Ensure proper storage of feed to prevent fungal contamination.
- Regularly clean water sources, feeders, and housing areas.
- Avoid prolonged use of antibiotics or steroids unless prescribed, as these can weaken the immune system.
Prognosis
The prognosis for ducks with aspergillosis varies depending on the severity of the infection and how quickly treatment begins. Mild to moderate cases may recover fully with proper care, while severe or chronic infections can be more difficult to resolve. Preventing reinfection through environmental improvements is essential for long-term success.
If you suspect aspergillosis in your duck, consult a veterinarian immediately to develop a tailored treatment plan and improve the chances of recovery.
Prevention and Control of Aspergillosis in Ducks
Preventing aspergillosis is essential for maintaining the health and well-being of your ducks. Since Aspergillus spores are found naturally in the environment, completely eliminating exposure is impossible, but you can minimize the risk by creating a clean and healthy living space for your flock.

Key Prevention Strategies
- Ensure Proper Ventilation
- Good airflow in duck housing is vital to prevent the buildup of moisture and heat, which create the perfect conditions for fungal growth.
- Use fans or ventilation systems, especially in enclosed areas, to keep air circulating and reduce humidity levels.
- Practice Good Sanitation and Biosecurity
- Regularly clean and disinfect the duck house, feeders, and waterers to remove potential sources of fungal spores.
- Isolate new or sick ducks from the flock to reduce the spread of any infectious agents, including Aspergillus.
- Store Feed Properly
- Store duck feed in airtight, moisture-proof containers to prevent mold growth.
- Avoid purchasing large quantities of feed that may spoil before it is used. Discard any feed that smells musty or shows signs of mold.
- Manage Bedding Effectively
- Remove wet, soiled, or moldy bedding at least once a week, or more frequently in damp conditions.
- Use absorbent materials like straw, wood shavings, or hemp bedding that can be replaced easily.
- Avoid Prolonged Use of Antibiotics
- Overuse of antibiotics or steroids can weaken ducks’ immune systems, making them more vulnerable to fungal infections. Use these medications only under veterinary guidance.
- Reduce Stress Factors
- Minimize stress by providing a consistent routine, ample space, and a quiet, predator-free environment.
- Avoid overcrowding, as this can lead to competition for resources and weaken ducks’ immune responses.

Additional Control Measures
- Monitor the Environment
- Test soil, water, or bedding for fungal contamination in areas where ducks show recurring respiratory issues.
- Use antifungal sprays or disinfectants in high-risk areas like wet ground or feed storage areas.
- Keep Outdoor Areas Dry
- Drain standing water in duck runs and yards to reduce moisture that promotes fungal growth.
- Raise housing structures off the ground and use pavers or gravel in outdoor spaces to improve drainage.
- Provide Nutritional Support
- Offer a balanced diet enriched with vitamins A, C, and E to strengthen ducks’ immune systems.
- Supplement with probiotics to support gut health, which can influence overall immunity.

By Implementing These Measures:
You create an environment that minimizes the conditions Aspergillus needs to thrive, significantly reducing the risk of infection. Prevention is always easier and more effective than treatment, so consistent care and proactive management are crucial for keeping your ducks healthy and happy.
By maintaining a clean, stress-free, and well-ventilated space, you’ll not only protect your ducks from aspergillosis but also foster a thriving, resilient flock!
Further Reading & Resources
- 16 Common Duck Health Conditions You Should Know About
- 31 Must-have Items for Your Pet Duck First Aid Kit
- How to Conduct a Duck Health Check: A Comprehensive Guide
- What is the Best Bedding for Ducks?
- Recognizing and Addressing Respiratory Conditions in Ducks
- Ducks Coughing: Causes, Symptoms, and Solutions
- The Duck Respiratory System: Airways, Lungs, and Air Sacs in Detail
Deepen your understanding of avian wellness. Explore the full Duck Health & Anatomy Library for more specialized care guides.
References
- El-Shemy, Ahmed et al. “Investigation of aspergillosis outbreak in young ducklings: Unraveling the role of hatcheries in Aspergillus fumigatus transmission.” Journal of advanced veterinary and animal research vol. 10,4 763-772. 31 Dec. 2023, doi:10.5455/javar.2023.j732
- Chung, Eric Lim Teik et al. “A case of aspergillosis outbreak in a broiler duck farm in Kelantan, Malaysia.” Journal of advanced veterinary and animal research vol. 7,4 692-697. 18 Nov. 2020, doi:10.5455/javar.2020.g469
- Hobbyfarms.com Aspergillosis In Ducks: How to Prevent & Treat
- Duck DVM: Aspergillosis
